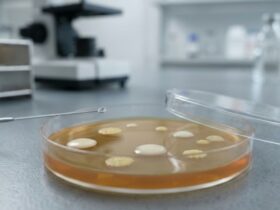

Sem comida, uma pessoa pode viver até três semanas e sem água — apenas alguns dias. Houve um tempo em que a água era usada com baldes, agora chega a casa através dos tubos. Você já pensou sobre por que os ancestrais se estabeleceram nos vales dos rios ou nas costas dos lagos e dos mares? Sim, claro, ao lado da água.
Regar água na casa foi um sonho que ganhou vida apenas no século XLX. Edifícios de madeira de cidades antigas e aquecimento do fogão levaram a incêndios frequentes. Aqui estão os bombeiros e se tornaram o primeiro encanador. Mas se a água foi levada para a habitação, é necessário removê -la. Então o sistema de esgoto apareceu. Isso é nas cidades. Os moradores da aldeia cavaram poços mais perto da casa. No verão, Aryki cavou ou colocou proibições em pequenos rios e levou o fluxo mais perto das casas.
A pessoa está acostumada ao fato de que sempre há água, apenas as mãos se estica. Portanto, mudando -se para o país ou para a casa de campo, o primeiro inconveniente é sempre manifestado na ausência de água. O suprimento de água em casa se torna a principal tarefa da vida suburbana. Água a pé e baldes na mão do balancim, como nossas avós fizeram, má ideia.
Primeiro de tudo, você precisa encontrar a fonte da qual desenhará água. É necessário um projeto, pelo menos um esboço. Tubo, filtros, válvulas e acessórios são preparados de acordo com o projeto. Ele também precisa de um tanque consumível, uma estrutura levantada 10 metros acima da superfície para criar pressão. Do recipiente, o tubo depositado para os edifícios é realizado. Se você planeja morar na casa no inverno, os canos devem ser aprofundados no chão.
Geralmente o carro de água da rua é realizado por canos com isolamento térmico. Além do isolamento, eles devem ocorrer em uma camada quente de terra. O tanque consumível deve ter uma válvula para drenar água e um portão de corte. O veículo de água de verão é colocado com uma inclinação para o dreno de água e no outono é libertado dos resíduos. Mas se a água fluir no ano, o tanque consumível também deve ser isolado.
Suponha que você tenha uma casa de campo e abastecimento de água de verão. Então você precisa ter seu próprio bem. Em todas as áreas, existem especialistas construindo tais estruturas. Sim, o poço é uma estrutura de engenharia. Você não quer beber água obtida da precipitação da fonte mais próxima. Agora encontrar água potável em um lago aberto não é fácil. O território europeu não tem mais rios de água limpa. A atividade do homem, o conquistador da natureza, levou à poluição total de seu produto vital.
Estamos construindo um poço
Deve ser profundo, ter um nível constante de água. Ao perfurar, eles passam para o segundo aqüífero, isolamento do primeiro, superficial. A primeira água está próxima da superfície, por isso está contaminada e não tem um nível constante. O dispositivo em forma de água tem suas próprias sutilezas. É necessário calcular a extração da água e sua regulamentação durante a construção. O excesso de fluido no poço leva à estagnação e ao odor desagradável. Com a instalação de uma bomba profunda e um pequeno consumível na sala isolada, você sempre terá água. E se você ainda adaptar a bomba da antiga máquina de lavar, então o suprimento para o moom será fornecido.
A terceira opção que não requer grandes custos será a inserção do oleoduto que passa pelo seu site. Isso não é feito arbitrariamente. Primeiro, coordenação com o proprietário. Em seguida, o projeto de conexão com parâmetros de uso. Sob as condições técnicas desenvolvidas, a pressão no tubo, o procedimento para a contabilização do consumo é escrito. Um esquema de fiação será definitivamente necessário. Um contrato é elaborado e você recebe água para todo o ano. Obviamente, para conectar seu suprimento de água, você terá que alinhar -se aos requisitos dos padrões de construção. Mas o suprimento ficará ininterrupto.
Estamos construindo uma rede de esgoto
Desde que a água entrou na casa, após o uso, ela deve ser retirada. Estamos construindo a rede de esgoto mais simples. Pessoas experientes aconselham a construção de estações de tratamento local, ou seja, um recipiente especialmente arranjado para águas residuais. É realizado de modo que a limpeza e o bombeamento de dois palcos de uma fração líquida purificada para irrigação de gramados seja possível. Canteiros de vegetais não devem ser regados com esta água. Uma fração firme permanece. Portanto, uma máquina especial deverá ser bombeada pelo menos uma vez por ano, dependendo das dimensões do recipiente para drenos e a quantidade de água usada.
O receptor de ações deve ser do poço pelo menos 20 metros. Isso é muito importante para que as águas residuais não sejam filtradas através do solo próximo à ingestão de água. Todos os tubos de esgoto são realizados em um tanque séptico no subsolo. Existem aditivos modernos com os quais o dreno é limpo e libertado de bactérias nocivas. Para recipientes de tratamento local, isso evitará um odor desagradável e transformará águas residuais em fertilizantes.
Ao se dar água e ter concluído o trabalho na instalação de esgoto, uma pessoa pode sentir a alegria de ficar fora da cidade em ar limpo. Agora você pode organizar sua vida. Você pode instalar um chuveiro, conectar uma máquina de lavar. E lembre -se da música sobre um hidromassagem alegre: “Porque sem água e não tudus, e não refrigerante”.
Uma internet com fio ou wifi ajudará a passar longas noites em uma solidão calma de uma casa de campo. O fio do cabo de vapor e fibra torcido é chamado para garantir a comunicação sustentável para acesso à rede. Leia mais no site.
Realizamos água e esgoto para a casa. Internet fora da cidade
5 (100%) 1

Оставить коммент.